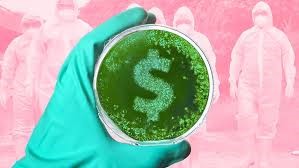

AIPE@INFORMA 18/2020 – L’IMPATTO ECONOMICO DELLA PANDEMIA SULL’ECONOMIA E SULL’ECONOMIA CIRCOLARE
AIPE@INFORMA 18/2020 - L'IMPATTO ECONOMICO DELLA PANDEMIA SULL'ECONOMIA E SULL'ECONOMIA CIRCOLARE
Devi eseguire l'accesso per visualizzare questo contenuto. Accedi
